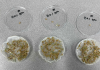

영광군 2026년 상반기 지역공동체 일자리사업 발대식 개최
작성 : 2026년 03월 03일(화) 14:35 가+가-

2026년 상반기 지역공동체 일자리사업 발대식
[톡톡뉴스]영광군은 지난 3일 영광군청 별관 2층 회의실에서 2026년 상반기 지역공동체 일자리사업 참여자 22명을 대상으로 발대식을 개최하고 산업안전보건교육을 실시했다.
지역공동체 일자리사업은 저소득층 및 장기실직자 등 취업취약계층의 생계유지 와 고용안정을 위해 실시하는 사업으로, 상반기는 3월부터 6월까지, 약 4개월 동안 실시한다.
활동 내용으로는 (문화재 상시관리 지원, 스포티움 환경정비, 영광군 소공원 정비, 공공하수 정비사업, 대마면 아름다운 꽃길 조성사업, 찰보리축제장 지내들돌탐공원, 백수해안도로 구절초 꽃동산 조성, 북종산 미륵산 구절초 꽃동산 조성)으로 근로자들은 산림공원과를 포함한 8개 실단과소 및 읍면에 배치되어, 소공원정비 및 마을을 아름답게 가꾸기 위해 부서별 특색있는 사업을 수행하게 된다.
영광군 관계자는 “지역공동체일 자리사업은 군민들에게 취업기회를 제공하는 것은 물론, 우리 마을을 아름답게 가꾸고 지역사회의 발전을 위해 초석을 다지는 사업이다” 면서 “참여자들이 긍지와 자부심을 가지고 적극적으로 사업에 참여해 주기를 바란다“고 말했다. 김미자 기자 기사 더보기
김미자 기자 기사 더보기
지역공동체 일자리사업은 저소득층 및 장기실직자 등 취업취약계층의 생계유지 와 고용안정을 위해 실시하는 사업으로, 상반기는 3월부터 6월까지, 약 4개월 동안 실시한다.
활동 내용으로는 (문화재 상시관리 지원, 스포티움 환경정비, 영광군 소공원 정비, 공공하수 정비사업, 대마면 아름다운 꽃길 조성사업, 찰보리축제장 지내들돌탐공원, 백수해안도로 구절초 꽃동산 조성, 북종산 미륵산 구절초 꽃동산 조성)으로 근로자들은 산림공원과를 포함한 8개 실단과소 및 읍면에 배치되어, 소공원정비 및 마을을 아름답게 가꾸기 위해 부서별 특색있는 사업을 수행하게 된다.
영광군 관계자는 “지역공동체일 자리사업은 군민들에게 취업기회를 제공하는 것은 물론, 우리 마을을 아름답게 가꾸고 지역사회의 발전을 위해 초석을 다지는 사업이다” 면서 “참여자들이 긍지와 자부심을 가지고 적극적으로 사업에 참여해 주기를 바란다“고 말했다.
최신뉴스더보기

- 영광군 2026년 상반기 전남인재육성 장학금, 4월 17일부터 5월 15일까지 신청
- [톡톡뉴스] 전남인재평생교육진흥원은 지역 인재의 외부 유출을 방지하고 지역 정착을 지원하기 위해 ‘2026년…

- 영광군, 제53회 전국대학태권도 개인선수권 대회 개최
- [톡톡뉴스] 영광군이 오는 23일부터 30일까지 8일간 제53회 전국대학태권도 개인선수권대회를 영광스포티움…

- 영광군, 경찰서와 체납차량 합동단속 실시
- [톡톡뉴스] 영광군은 금년 3월부터 10월까지 매월 마지막 주 목요일을 '체납차량 번호판 일제단속의 날'로…

- 영광군, 토요 감성 힐링 여행 「영광 쉼 투어」 시작
- [톡톡뉴스] 영광군은 4월 18일부터 10월 31일까지(7∼8월 폭염으로 제외) 토요 감성 힐링 여행‘202…

- 영광군 노인복지관 맞춤형 감염병 예방교육 실시 ‘예방이 최고의 치료’
- [톡톡뉴스] 영광군은 지난 16일 노인복지관 회원 30여명을 대상으로 감염병 예방교육을 실시했다고 밝혔다. …

- 영광군, 귀농교육생 대상 선배 귀농인 농가 현장견학 실시
- [톡톡뉴스] 영광군은 지난 15일 농업기술센터에서 주관하는‘상반기 귀농?귀촌인 영농기초 기술교육’ 과정에 참…

- 영광군미래교육재단, 2026년 영광군인재육성장학금 5월 8일까지 신청
- [톡톡뉴스] 영광군미래교육재단은 지역 인재 발굴 및 육성을 위해 ‘2026년 영광군 인재육성장학금’지원 대상…
- 영광군, 벼농사 시작 전 ‘종자 발아율’ 무료 검사 받으세요.
- [톡톡뉴스] 영광군은 본격적인 영농철을 앞두고 건전한 육묘를 돕기 위해 벼 종자 발아율 사전검사를 무료로…

- 봄바람 따라 찾아온 붉은 버베나, 불갑사 일주문이 꽃길로 변했어요!
- [톡톡뉴스] 영광군은 봄을 맞아 불갑사 일주문 일원에 붉은 버베나 꽃으로 화분을 설치하고 붉은색 테마 식재를…

- 영광군립도서관, 직장인을 위한 야간 특별프로그램 선보여
- [톡톡뉴스] 영광군에서는 평일 주간에 도서관 이용이 어려운 직장인을 대상으로 야간 독서문화프로그램 ‘퇴근길,…
Copyright © 2016 뉴스톡톡. All Rights Reserverd.

